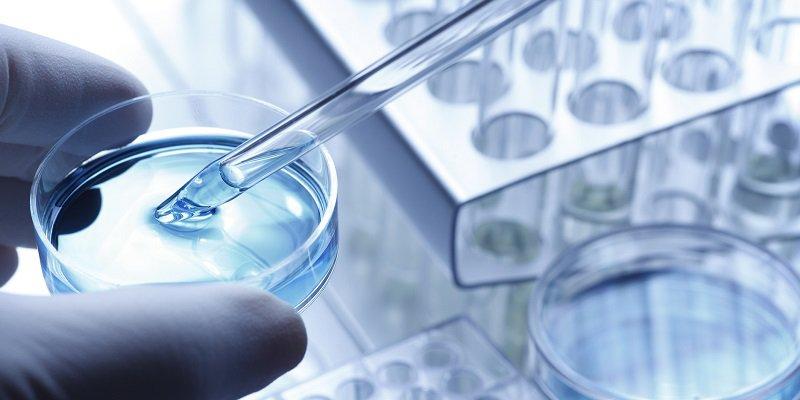

Patrocinado
Unlock Big Wins with Joker123 APK: Your Guide to Mobile Slot Gaming

Mobile gaming has revolutionized the way we experience online casinos, offering players the freedom to play their favorite games anywhere, anytime. If you’re a fan of slot games and looking for an exciting, user-friendly platform to play on your smartphone, look no further than Joker123 APK. With an extensive collection of thrilling slots, generous bonuses, and smooth mobile performance, Joker123 APK is the ultimate mobile casino app to unlock big wins joker123 motobola slot demo.
In this guide, we’ll walk you through everything you need to know about Joker123 APK and how to use it to enhance your mobile slot gaming experience. Whether you’re new to online slots or a seasoned player, this guide will help you get the most out of the Joker123 APK and increase your chances of hitting those big jackpots.
What is Joker123 APK?
Joker123 APK is the mobile version of the popular Joker123 online casino platform, specifically designed for Android devices. By downloading and installing the Joker123 APK, you can enjoy a wide range of slot games, live casino games, table games, and jackpots, all optimized for mobile play. The app is easy to install, offers a seamless gaming experience, and ensures that you can access your favorite games with just a tap of a finger.
Whether you’re on the go or relaxing at home, Joker123 APK brings the full casino experience to your mobile device, giving you the chance to win big with just a few spins.
Why Choose Joker123 APK for Mobile Slot Gaming?
There are many online casinos and mobile apps available, but Joker123 APK stands out for several reasons, particularly when it comes to mobile slot gaming:
1. A Wide Variety of Slot Games
Joker123 APK offers an extensive selection of slot games, ranging from traditional 3-reel slots to modern 5-reel video slots, ensuring that there’s something for every type of player. Whether you prefer simple, straightforward slots or more complex ones with exciting bonus features, Joker123 APK has you covered.
-
Classic Slots: These are perfect for players who enjoy the simplicity of traditional slots, offering familiar gameplay with a nostalgic feel.
-
Video Slots: For players looking for something more immersive, Joker123 APK offers a variety of video slots with engaging themes, captivating storylines, and exciting bonus rounds that add an extra layer of excitement to the experience.
-
Progressive Jackpots: Want the chance to win a massive prize? Joker123 APK features several progressive jackpot slots where the jackpot grows with every bet placed, offering the opportunity for life-changing wins.
-
New Releases: Joker123 APK regularly updates its slot library, ensuring that there’s always something new and fresh to try. With new themes, mechanics, and features constantly being added, there’s never a dull moment when playing Joker123 slots.
2. Optimized for Mobile Play
One of the standout features of Joker123 APK is its mobile optimization. The app has been designed to deliver smooth, responsive gameplay on Android devices, ensuring that you have a hassle-free experience no matter where you are.
-
Seamless Gameplay: Joker123 APK runs smoothly on a variety of Android devices, from smartphones to tablets, ensuring that you can enjoy the same great graphics and features as the desktop version. The controls are optimized for touchscreens, allowing for a user-friendly and enjoyable experience.
-
Fast Loading Times: The Joker123 APK is designed to load quickly, even on mobile data, so you won’t have to wait long to start playing your favorite slot games. Whether you’re at home or on the go, the app’s fast performance ensures that you can play without interruption.
-
High-Quality Graphics: The game graphics are sharp and vibrant, bringing the immersive slot game themes to life on your mobile device. Whether you’re playing a simple classic slot or a feature-packed video slot, the visuals are designed to keep you engaged and entertained.
3. Big Wins with Bonuses and Features
To help maximize your chances of winning big, Joker123 APK offers a variety of bonuses and features that enhance the slot gaming experience. These bonuses can give you extra spins, boost your chances of hitting big payouts, or even unlock massive progressive jackpots.
-
Free Spins: Many slot games on Joker123 APK feature free spins, which allow you to play additional rounds without wagering your own funds. Free spins are often triggered by landing specific symbols or hitting certain bonus combinations.
-
Bonus Rounds: Joker123 APK slots often feature exciting bonus rounds, where you can unlock multipliers, extra rewards, or even mini-games. These bonus features add depth to the gameplay and provide more opportunities to win big.
-
Progressive Jackpots: Progressive jackpots are a standout feature in many of the slot games available on Joker123 APK. These jackpots increase with every bet placed, creating the potential for massive, life-changing payouts.
-
Daily and Weekly Promotions: Joker123 APK also offers regular promotions for players, including reload bonuses, cashback offers, and other incentives. These promotions help keep the gaming experience fresh and rewarding, giving you more chances to win.
4. Easy to Download and Install
Getting started with Joker123 APK is easy and straightforward. You can download the APK file directly from the official Joker123 website and install it on your Android device in just a few simple steps. Here's a quick guide to getting started:
- Enable Unknown Sources: Before downloading the APK, go to your device’s settings and enable the option to install apps from unknown sources.
- Download the APK: Visit the official Joker123 website and download the latest APK file.
- Install the APK: Open the downloaded file and follow the prompts to install the app.
- Create an Account: Once installed, open the app, create an account or log in, and start playing!
5. Secure and Reliable
Joker123 APK ensures that your personal information and gaming data are kept safe with encryption technology. The platform also uses a Random Number Generator (RNG) to ensure fair play, meaning that every spin is completely random and unbiased. This commitment to security and fairness allows you to enjoy your mobile slot gaming experience with peace of mind.
Tips for Maximizing Your Wins on Joker123 APK
-
Choose Slots with High RTP: RTP (Return to Player) is a percentage that indicates how much a slot game will pay back to players over time. Look for slots with a high RTP to increase your chances of winning.
-
Take Advantage of Bonuses: Be sure to claim any bonuses or promotions available on Joker123 APK to maximize your gameplay and boost your chances of winning big.
-
Set a Budget: While it's easy to get caught up in the excitement, setting a budget for your gaming session can help you manage your spending and keep the experience fun.
-
Play Progressive Jackpots: For the chance to win life-changing prizes, try your luck with the progressive jackpot slots available on Joker123 APK joker123 motobola slot demo.
Conclusion
Joker123 APK is the perfect mobile gaming solution for slot enthusiasts who want to unlock big wins on the go. With a vast selection of exciting slot games, optimized mobile gameplay, rewarding bonuses, and secure transactions, Joker123 APK delivers an unmatched casino experience directly to your fingertips. Whether you're playing for fun or aiming for massive jackpots, Joker123 APK ensures that every spin has the potential to bring you closer to your next big win.
So why wait? Download Joker123 APK today and start spinning your way to big wins with the best mobile slot gaming experience!
Categorias
Leia mais
The healthcare and pharmaceutical sectors are continually expanding, and clinical research is vital to providing novel products and treatments to patients throughout the world. If you want to make a difference in the medical industry, doing a clinical research course could be a game changer for your future. It not only gives academic knowledge, but it also prepares you for the practical...
In a city like Kuala Lumpur, known for its skyline, multicultural vibrancy, and sophisticated lifestyle, personal connection often takes on a more exclusive meaning. In this world of high expectations and tight schedules, a KL Escort Girl provides the perfect solution for those who desire elegant, intelligent, and private companionship. More than just a beautiful presence, a KL Escort Girl...



